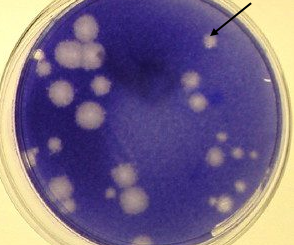

२६-०८-२०२५ | जीवाणूला खाणारा विषाणू
निसर्गात सर्वसाधारणपणे तीन प्रकारचे विषाणू असतात. प्राणीपेशीवर वाढणारे विषाणू, वनस्पतीपेशीवर वाढणारे विषाणू आणि जीवाणूवर वाढणारे विषाणू. जीवाणूच्या पेशीत वाढणार्या विषाणूला ‘बॅक्टेरिओफाज’ असे म्हणतात. विषाणू या सुक्ष्मजीवांचे महत्वाचे लक्षण म्हणजे ते जिवंत पेशीमध्ये वाढतात. एखाद्या द्रवात […]









